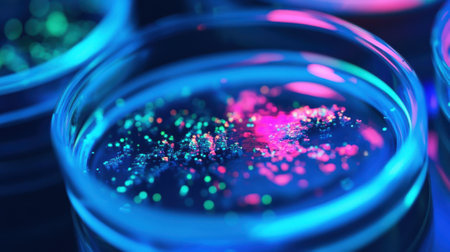
A closeup of a petri dish containing genetically modified cells glowing under fluorescent light. The cells exhibit distinctive characteristics as part of a CRISPR screening projecの素材

素材 - A closeup of a petri dish containing genetically modified cells glowing under fluorescent light. The cells exhibit distinctive characteristics as part of a CRISPR screening projec
作品情報
A closeup of a petri dish containing genetically modified cells glowing under fluorescent light. The cells exhibit distinctive characteristics as part of a CRISPR screening projec
- ID:276199760
- 作品種別:
- 作者名:justlight77
キーワード
- automated
- biology
- bioluminescence
- biotechnology
- cells
- characteristics
- containing
- crispr
- dish
- distinctive
- editing
- engineering
- exhibit
- experimental
- fluorescent
- gene
- genetic
- genetically
- genome
- glowing
- laboratory
- light
- modification
- modified
- molecular
- part
- petri
- project
- screening
- successful
- techniques
- underlining
類似作品
Background with...
Backgrounds of ...
Shimmer bubbles...
Pouring liquid ...
Backgrounds of ...
Microbiology La...
Microbiology La...
Backgrounds of ...
Viruses and bac...
Petri dish with...
Viruses and bac...
photo of fungi ...
top view petri ...
Microbiology la...
Bacterial colon...
Petri dishes wi...
Petri dish with...
A closeup shot ...
Young male chem...
Colony characte...
Laboratory tech...
A researcher in...
Mold Beautiful,...
hand of scienti...
Molds colonies ...
Out focus bood ...
Optochin subsen...
photo of fungi ...
Penicillium, as...
Colonies of mic...
Backgrounds of ...
epidemic and th...
Backgrounds of ...
Research of vir...
Scientist Works...
Detail of two p...
Test tube next ...
white mold grow...
Laboratory tech...
Pipette with dr...
Germination and...
Backgrounds of ...
Characteristics...
Petri dishes in...
chemist wearing...
Test tubes flas...
Petri dishes wi...
Colonies of bac...
Staphylococcus ...